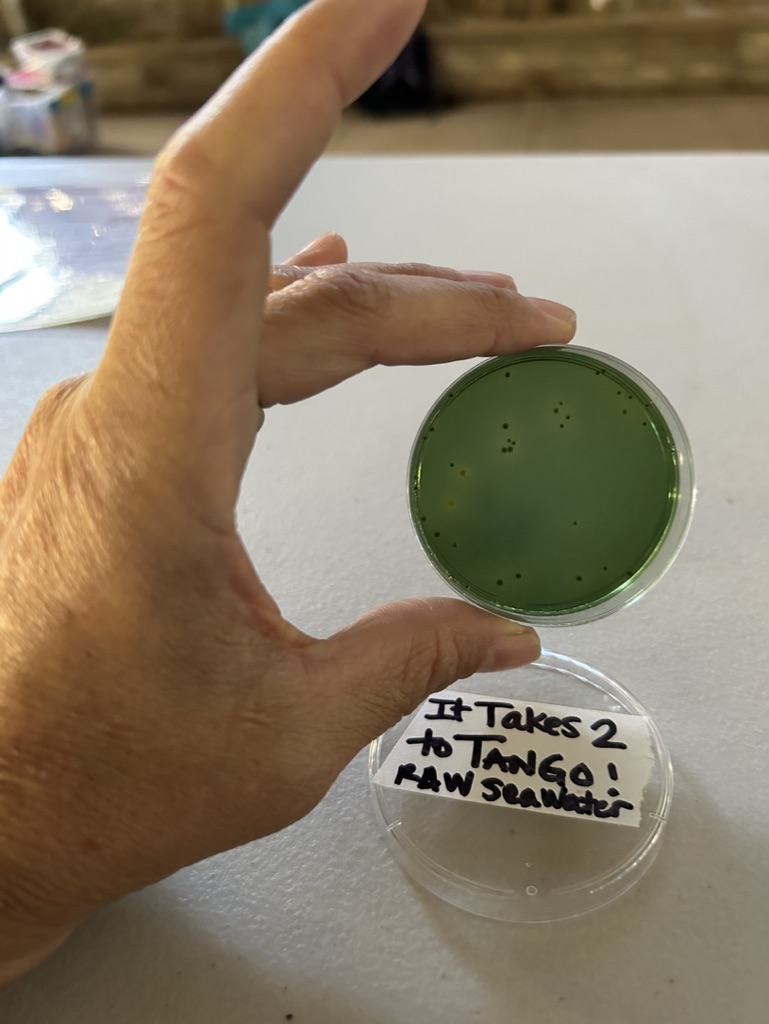

Overview
The 2023 White Abalone Spawning and Culture Workshop, hosted by the The Cultured Abalone Farm (TCAF) and organized by Nora Frank (UC Davis, Bodega Marine Lab) and Devin Spencer (TCAF), brought together participants from every partner institution working on white abalone restoration. With a unique mix of hands-on activities and expert lectures, the workshop covered the entire spawning and culturing process for white abalone, from broodstock selection to larval culture and microalgae conditioning. The workshop also facilitated collaboration with abalone researchers focused on restoration, including those working on pinto abalone. Valuable insights from the workshop have already led to operational improvements and successful spawning at other institutions.






Workshop Scope and Goals
The workshop aimed to:
- Foster collaboration across institutions engaged in abalone conservation and captive rearing.
- Educate participants on essential spawning and culturing practices, focusing on white abalone but extending to broader restoration practices.
- Share advancements in abalone health assessments, spawning techniques, and larval rearing.
- Build a foundation for ongoing collaboration between partner institutions and set a precedent for future workshops in abalone restoration.

Core Skills and Techniques
Throughout the workshop, participants delved into essential aspects of white abalone spawning and culturing, gaining hands-on experience and a foundational understanding to enhance restoration practices. They learned how to prepare for spawning by assessing broodstock health and identifying mature gonads, followed by guided training on the spawning and fertilization processes. Key discussions included managing water quality, maintaining optimal fertilization rates, and addressing Vibrio sp. bacteria, a common challenge in abalone culture.




In addition to spawning techniques, the workshop emphasized post-spawn larval care and settlement preparation. Participants practiced larval settlement procedures and developed skills in culturing microalgae, crucial for nourishing young abalone. With each activity, attendees strengthened their understanding of abalone husbandry, preparing them to apply these protocols and foster sustainable growth in their facilities.




Workshop Impact
The workshop successfully equipped participants with the tools to improve their husbandry and spawning practices. Knowledge gained led to more streamlined processes for juvenile preparation and inspired a successful spawning at Moss Landing Marine Laboratories (MLML) shortly afterward. Collaborative efforts, like those with the University of Alaska Fairbanks for pinto abalone restoration, underscore the workshop’s broader impact on abalone conservation.
